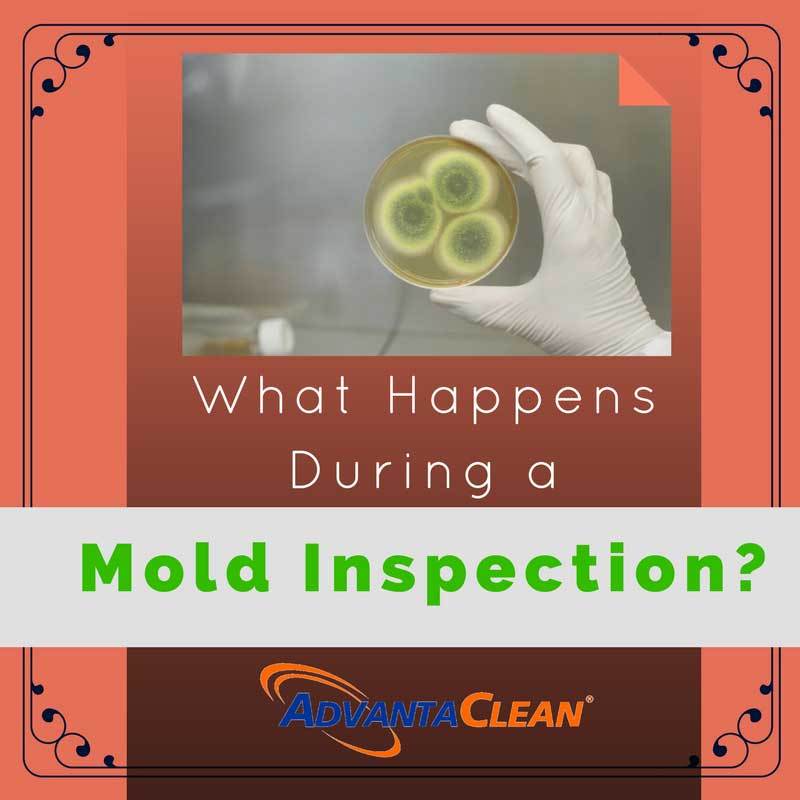

Get 1/2 Off This Service with Full Duct Cleaning!
Our team of professionals has the knowledge needed to handle flood damage projects.
Posted: Nov 28, 2016
Author: AdvantaClean of West Knoxville
As you would expect, a mold inspection is a thorough search of your home or business to find out whether mold is growing, where it is, and what encouraged its growth. Because of this, it will involve finding the actual mold and searching for water problems; after all, mold tends to grow in humid or moist areas.
Get 1/2 Off This Service with Full Duct Cleaning!
We Service
AdvantaClean of West Knoxville provides service in the following and surrounding areas: Knoxville, Farragut, Oak Ridge, Madisonville, Friendsville, Greenback, Kingston, Lenoir City, Loudon, Maryville, Sweetwater
Mold Inspection, Knoxville, TN · Sewage Removal, Knoxville, TN · Duct & Vent Cleaning Services, Knoxville, TN · Ductwork Cleaning, Knoxville, TN · Basement Flood Cleanup, Knoxville, TN · Duct Cleaning, Knoxville, TN · Duct Cleaning Services, Knoxville, TN · Vent Cleaning Services, Knoxville, TN · Water Leak, Knoxville, TN · Mold Cleanup, Knoxville, TN · Flooding, Knoxville, TN · Vent Cleaning, Knoxville, TN
Powered By : WordJack Media | © AdvantaClean of West Knoxville | Privacy Policy